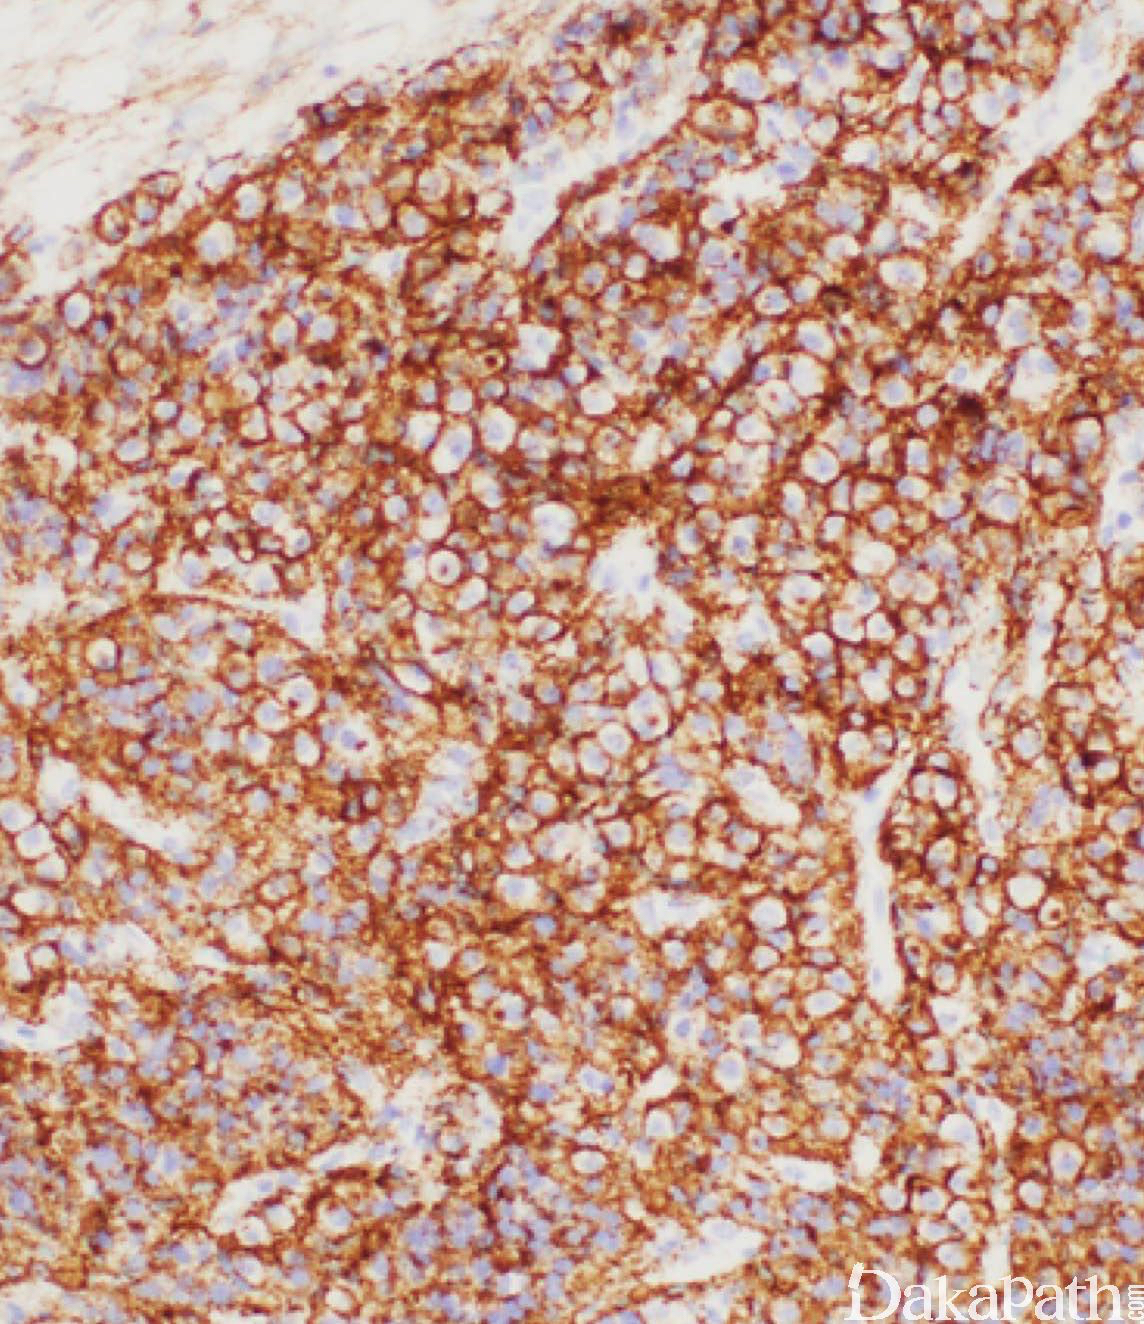

肾脏浆细胞瘤
Renal Plasmacytoma
发病部位: 肾脏
诊断要点:
- 多数为进展期多发性骨髓瘤的肾内扩散,原发的肾脏内髓外浆细胞瘤非常罕见;
- 组织学上与其他部位浆细胞瘤相同;
- 在诊断肾脏原发性浆细胞瘤之前,应做全面的实验室和影像学检查以除外尚有其他部位的浆细胞瘤及浆细胞骨髓瘤。

免疫组织化学染色:
表达 CD79a,MUM1. CD38 和 CD138,不表达 PAX8 和 GATA3 以及 CK 等
鉴别诊断:
浆细胞样变异型尿路上皮癌:通常与普通型高级别尿路上皮癌并存,可表达 CD38 和 CD138,但表达 CK、P63 和 GATA3 不表达 CD79a 可资鉴别。
预后:
多发性骨髓瘤累及肾脏预后较差
治疗:
放化疗
病例报道:
Renal plasmacytoma: Report of a rarecaseand review of the literature.
参考文献:
T C, Igel;D E, Engen;P M, Banks;G L, Keeney. Renal plasmacytoma: Mayo Clinic experience and review of the literature. Urology,1991,37:385-9.
